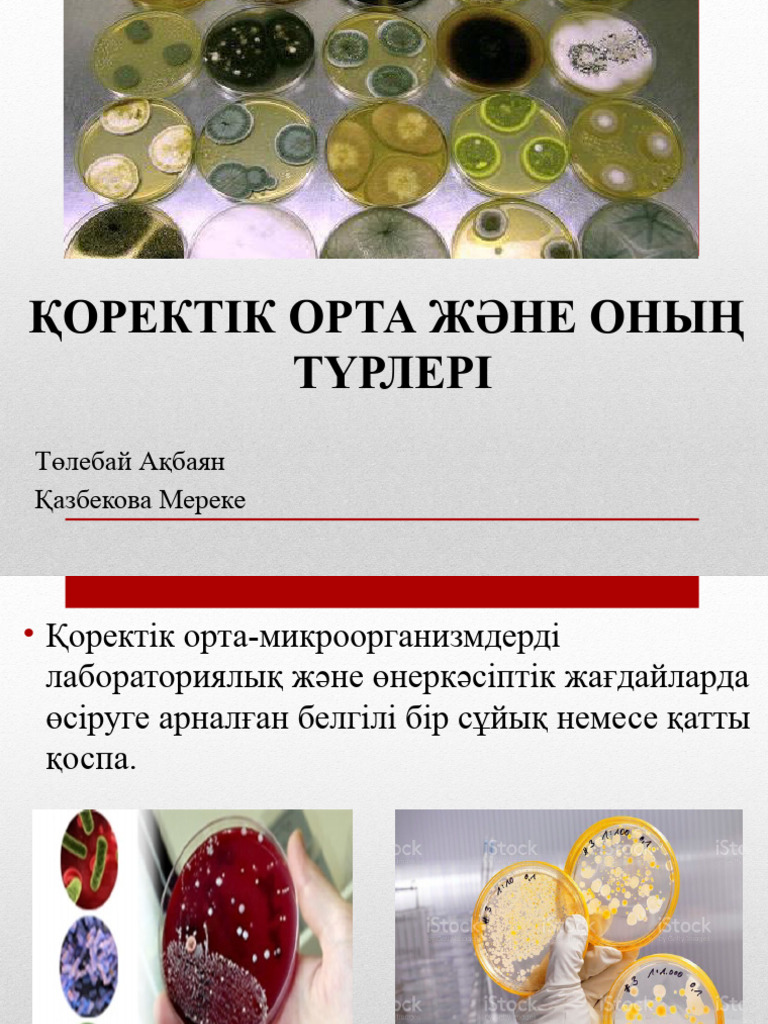
Алетта Мұхит және лас машина

Лесбияндық оргия спринттік сұйықтық
Отбасында жыныстық үйлесімділік, эмоция мен кеңестері, құпия эротикалық видео және кеңесі, эмоциялық бақыт пен түсіністік.









Отбасында жыныстық үйлесімділік, эмоция мен кеңестері, құпия эротикалық видео және кеңесі, эмоциялық бақыт пен түсіністік.